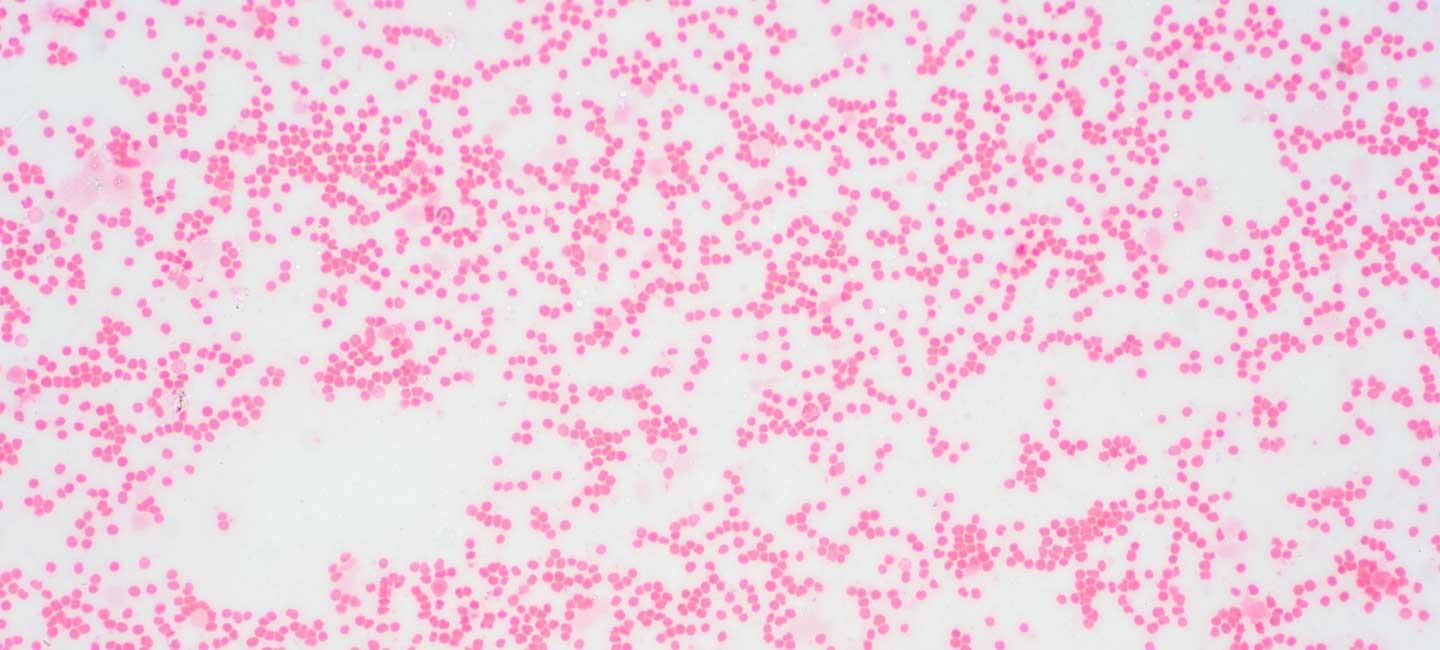

New Therapy Shows Promise for Myelodysplastic Syndrome Patients
In recent years hypomethylating agents (HMA) have been used to treat high-risk patients with myelodysplastic syndrome (MDS), a type of blood cancer where bone marrow produces blood cells that don’t mature. These drugs can help reactivate tumor-suppressing genes leading to killing of the cancer cell.
But what happens when these drugs don’t have the desired response? Researchers at Moffitt Cancer Center are hoping to find a new way to help patients whose tumors fail to respond or who progress after initially responding.
Join Dr. David A. Sallman of @MoffittNews at 3:15 p.m. tomorrow at #ASH22 for the phase 1 results of the first in-class CXCR1/2 inhibitor SX-682 in patients with hypomethylating agent failure myelodysplastic syndromes. @ASH_hematology Read more ➡️ https://t.co/VcBCss7LzL pic.twitter.com/kEHq11TpQy
— Moffitt Cancer Center (@MoffittNews) December 11, 2022
“The challenge is that for those patients who fail on hypomethylating agents, there’s really no standard of care,” said Dr. David Sallman, a hematologist in the Malignant Hematology Program at Moffitt. “There’s no targetable mutations, unlike in AML patients. These patients really have little to no options.”
Sallman is leading a phase 1 study looking at the effectiveness of SX-682, an oral drug that inhibits the CXCR1 and CXCR2 receptors. Results were presented as an oral presentation at the 2022 American Society of Hematology Annual Meeting and Exposition.
“It’s a pill that blocks a very specific receptor on leukemia cells,” said Sallman. “It can help kill the underlying leukemia MDS stem cell. Additionally, it can also kill a bad immune cell that is a major driver of low blood counts in MDS. The goal is a dual pronged approach where you can restore blood counts via effective killing of the underlying cancer cell while simultaneously depleting adverse immune cells.”

The study was funded by NHLBI grant HL142389 and looked at 17 MDS patients who received SX-682 with doses escalating from 25 to 400 mg in continuous 28-day cycles. Each of the participants had previously failed with HMA treatments. The goal of the study was to measure the safety and efficacy of SX-682 in the different dose sizes.
“When we look at safety it’s been very well tolerated,” said Sallman. “We’ve had no severe reactions that have prevented us from going to the maximum dose. Importantly, we haven’t had any bad infection-related complications despite an expected transient drop in white blood cells,” specifically neutrophils
Based on the totality of data, the recommended dose of SX-682 will be 200 mg given twice a day when used as the main form of therapy.
“When we looked at the overall response rate, the higher we went the more patients responded,” said Sallman. “When we look at the dose we’re going to be testing moving forward, we had some patients that had very significant improvement of platelet counts. We had one patient who was very dependent previously on blood transfusions who because transfusion free for over four months and was on study drug for around 18 months.”
With around half of patients showing a response to SX-682, the study will now expand to start testing patients who are earlier in their treatment plan while additionally testing more patients who have failed HMA therapy. Researchers will also look at SX-682 in combination with hypomethylating agents in 2023.